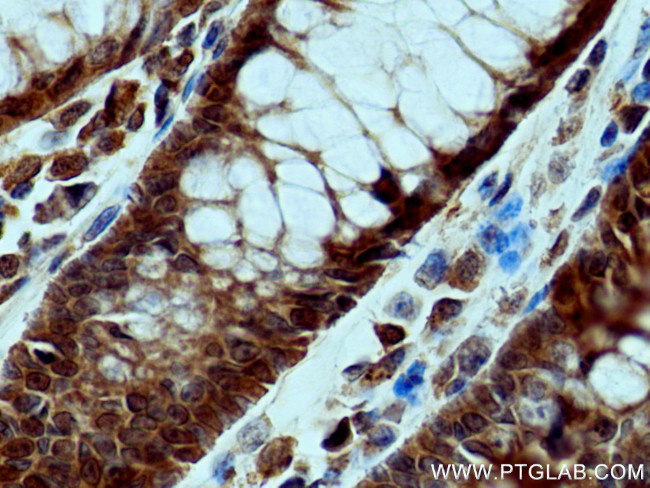
FES Antibody in Immunohistochemistry (Paraffin) (IHC (P))

Search
Proteintech
FES Polyclonal Antibody
{{$productOrderCtrl.translations['antibody.pdp.commerceCard.promotion.promotions']}}
{{$productOrderCtrl.translations['antibody.pdp.commerceCard.promotion.viewpromo']}}
{{$productOrderCtrl.translations['antibody.pdp.commerceCard.promotion.promocode']}}: {{promo.promoCode}} {{promo.promoTitle}} {{promo.promoDescription}}. {{$productOrderCtrl.translations['antibody.pdp.commerceCard.promotion.learnmore']}}
产品信息
28194-1-AP
种属反应
宿主/亚型
分类
类型
抗原
偶联物
形式
浓度
规格
纯化类型
保存液
内含物
保存条件
运输条件
产品详细信息
Aliquoting is unnecessary for -20°C storage.
靶标信息
FES (FPS) is a tyrosine protein kinase that is required for maintenance of cellular transformation. Its chromosomal location is linked to a specific translocation event identified in patients with acute promyelocytic leukemia, and it is also involved in normal hematopoiesis. Alternative splicing results in multiple variants encoding different isoforms.
仅用于科研。不用于诊断过程。未经明确授权不得转售。
篇参考文献 (0)
生物信息学
蛋白别名: c-fes; EC 2.7.10.2; feline sarcoma (Snyder-Theilen) viral (v-fes)/Fujinami avian sarcoma (PRCII) viral (v-fps) oncogene homolog; feline sarcoma oncogene; Feline sarcoma/Fujinami avian sarcoma oncogene homolog; Oncogene FES, feline sarcoma virus; p93c-fes; Proto-oncogene c-Fes; Proto-oncogene c-Fps; proto-oncogene tyrosine-protein kinase Fes/Fps; Tyrosine-protein kinase Fes/Fps; tyrosine-specific kinase; unnamed protein product; Variant 4
基因别名: FES; FPS
UniProt ID: (Human) P07332
Entrez Gene ID: (Human) 2242